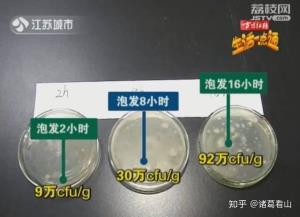

木耳泡發(fā)最佳時(shí)長(zhǎng)揭秘,掌握技巧,泡發(fā)恰到好處
木耳,作為一道既營(yíng)養(yǎng)又脆嫩的健康食材,廣受消費(fèi)者喜愛(ài),在享受其美味的同時(shí),我們也不應(yīng)忽視木耳泡發(fā)的時(shí)間,木耳泡發(fā)多久最為適宜呢?本文將為您詳細(xì)解析木耳泡發(fā)的最佳時(shí)間與技巧,助您烹飪出更加美味的木耳佳肴。
木耳泡發(fā)時(shí)間的重要性
泡發(fā)時(shí)間對(duì)木耳的品質(zhì)有著顯著影響:
1. **口感影響**:泡發(fā)時(shí)間過(guò)長(zhǎng),木耳會(huì)變得過(guò)于軟爛,口感大打折扣;反之,泡發(fā)時(shí)間過(guò)短,木耳不易入味,同樣影響口感。
2. **營(yíng)養(yǎng)影響**:泡發(fā)時(shí)間過(guò)長(zhǎng)會(huì)導(dǎo)致木耳中的營(yíng)養(yǎng)成分流失,降低其營(yíng)養(yǎng)價(jià)值;泡發(fā)時(shí)間過(guò)短,則可能無(wú)法充分吸收木耳中的營(yíng)養(yǎng)成分。
3. **安全性影響**:泡發(fā)時(shí)間過(guò)長(zhǎng),木耳容易滋生細(xì)菌,食用后可能引發(fā)食物中毒,因此掌握正確的泡發(fā)時(shí)間至關(guān)重要。
木耳泡發(fā)的最佳時(shí)間
1. **干木耳**:通常情況下,干木耳的泡發(fā)時(shí)間控制在30分鐘至1小時(shí)為宜,具體時(shí)間需根據(jù)木耳的干濕程度和室溫來(lái)調(diào)整,若木耳較為干燥,泡發(fā)時(shí)間可適當(dāng)延長(zhǎng);室溫較高時(shí),泡發(fā)時(shí)間則可適當(dāng)縮短。
2. **鮮木耳**:鮮木耳泡發(fā)時(shí)間較短,一般僅需5-10分鐘即可,由于鮮木耳本身含水量較高,泡發(fā)時(shí)間過(guò)長(zhǎng)反而會(huì)使口感變差。
木耳泡發(fā)的技巧
1. **使用溫水**:溫水泡發(fā)木耳,既能縮短泡發(fā)時(shí)間,又能更好地保留營(yíng)養(yǎng)成分。
2. **避免光直射**:將木耳放置在陰涼處泡發(fā),避免陽(yáng)光直射,以免影響木耳的口感和營(yíng)養(yǎng)價(jià)值。
3. **定期換水**:泡發(fā)過(guò)程中,應(yīng)定期更換清水,以去除木耳中的雜質(zhì)和細(xì)菌。
4. **控制泡發(fā)量**:泡發(fā)木耳時(shí),應(yīng)根據(jù)實(shí)際需求控制泡發(fā)量,避免浪費(fèi)。
5. **避免化學(xué)物質(zhì)**:不要使用洗衣粉、漂白劑等化學(xué)物質(zhì)泡發(fā)木耳,以免影響口感和安全性。
木耳泡發(fā)后的處理
1. **清洗**:泡發(fā)后的木耳應(yīng)徹底清洗干凈,去除雜質(zhì)和泥沙。
2. **切片**:根據(jù)菜肴需求,將木耳切成合適的片狀。
3. **烹飪**:將處理好的木耳進(jìn)行烹飪,如炒、燉、涼拌等多種方式。
干木耳泡發(fā)時(shí)間為30分鐘至1小時(shí),鮮木耳泡發(fā)時(shí)間為5-10分鐘,掌握木耳泡發(fā)的最佳時(shí)間與技巧,不僅能提升口感,還能保留營(yíng)養(yǎng)成分,確保食用安全,希望本文能為您的烹飪之路提供幫助。
相關(guān)閱讀:
1、西梅過(guò)量攝入的危害與后果揭秘
2、豬梅花肉,揭秘美食中的神秘部位
3、臘腸家常美味炒菜秘籍大揭秘!
4、燕窩價(jià)格揭秘,品質(zhì)與價(jià)值的平衡點(diǎn)
5、烘焙秘籍大揭秘,面粉與泡打粉比例大公開
相似問(wèn)題
- 木耳泡發(fā)最佳時(shí)長(zhǎng)揭秘,掌握技巧,泡發(fā)恰到好處
- 木耳炒制時(shí)間與技巧揭秘,美味健康兩不誤!
- 木耳泡發(fā)保存技巧揭秘,最佳時(shí)間與方法大公開
- 木耳快速泡發(fā)秘籍,輕松掌握泡發(fā)技巧!
- 木耳儲(chǔ)存保鮮攻略,揭秘木耳保質(zhì)期與延長(zhǎng)食用壽命秘訣
- 輕松泡發(fā)木耳,家常美味一步到位
- 木耳泡發(fā)時(shí)間大揭秘,掌握技巧,快速泡發(fā)木耳
- 木耳保鮮技巧大揭秘,延長(zhǎng)保質(zhì)期攻略
- 泡發(fā)木耳的最佳保存時(shí)間及注意事項(xiàng)揭秘
- 快速泡發(fā)木耳的省時(shí)省力技巧全解析
- 上一篇: 咸菜保存秘籍,延長(zhǎng)保質(zhì)期的實(shí)用技巧
- 下一篇: 返回列表